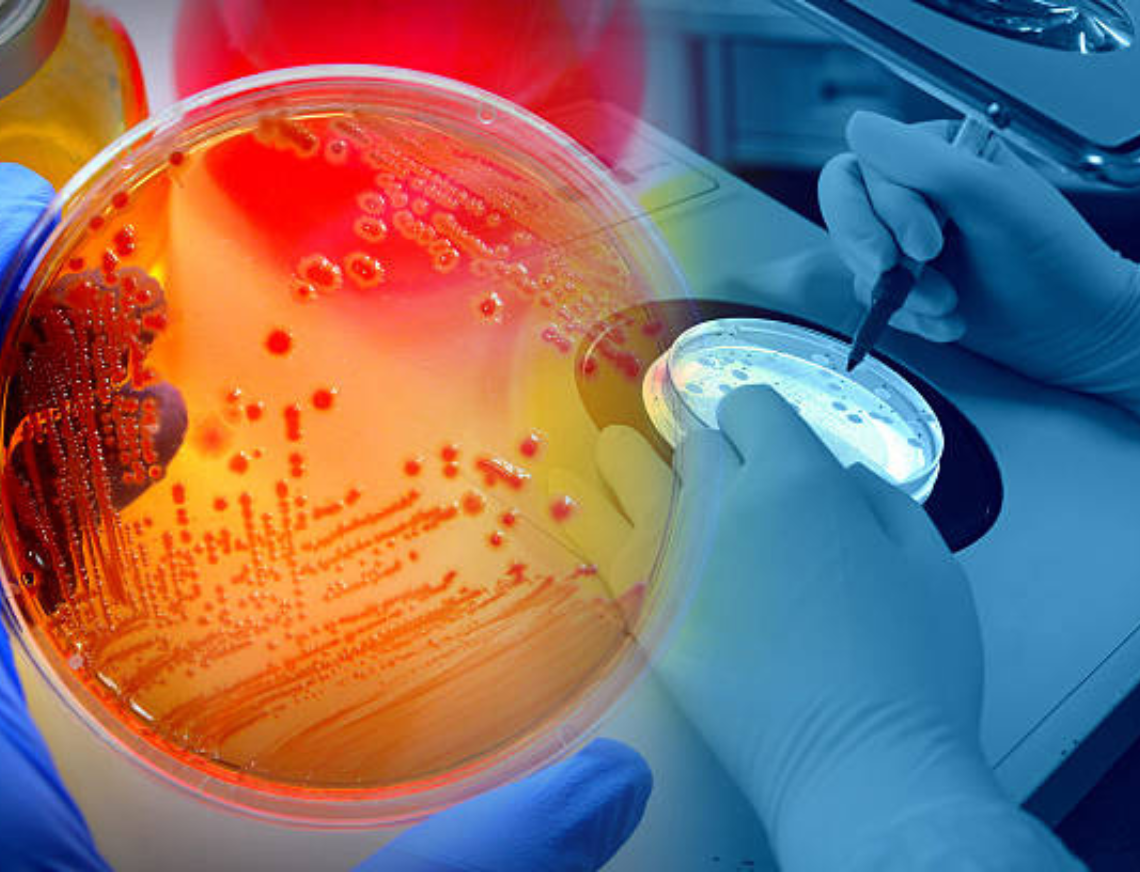
media.Progetto senza titolo - 2023-01-31T094052.819

Sali fino al quinto piano: le Suite Infinity e Incanto ti apriranno un magico mondo. Linee minimali e preziosi elementi di design regalano emozioni uniche tutte per te o da condividere insieme a chi ami.

Se stai cercando un hotel "comodo" in occasione del prossimo congresso AMCLI il Savini di Igea Marina è la scelta perfetta: qui sei a soli 5 minuti dal casello Rimini Nord e te ne servono solo 20 per raggiungere il Palacongressi di Rimini seguendo un percorso senza lo stress del traffico o dei semafori, lungo la Strada Statale 16 Adriatica.
Vuoi essere sicuro di non rimanere imbottigliato nelle lunghe code, la sera, al rientro in albergo? Prenota al Savini! Chiamaci subito per un' offerta in convenzione!
Al Savini puoi prenotare un posto auto riservato oppure puoi sempre contare su un parcheggio gratuito.
Tutte le camere hanno vista mare, ambienti ampi e moderni con esclusivi arredamenti di design. In più : Suite Incanto (48 mq) e Suite Infinity (58 mq), un lusso discreto con terrazzo panoramico sul mare e doccia Sweet SPA.
Per ben cominciare la giornata ti aspetta una colazione ricca e genuina con ottima caffetteria e proposte dolci e salate. E la sera, dopo una giornata intensa al congresso, potrai sempre contare sul ristorante Infinity del Savini per cenare gustando tutto il buono dei pesci del nostro mare ed i sapori della nostra tradizione. La cucina espressa di Chef Morri propone menù à la carte e menù in convenzione per cene aziendali.
Al Savini trovi piccoli lussi e speciali comfort per il tuo soggiorno di lavoro: dalla colonnina per la ricarica elettrica della tua auto al WI-FI veloce e gratuito, dal servizio navetta su richiesta alla disponibilità di sale riunioni attrezzate per meeting o presentazioni.
SAVINI: soggiorno business FRONTE MARE
Il lavoro ti porta in Riviera Romagnola? Ecco il mix perfetto per un soggiorno tra business e relax